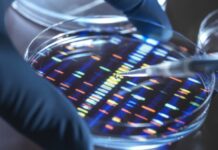
Врач Колесникова: вклад генетики в развитие алкогольной зависимости составляет до 65%

УНИАН: в Киеве мужчина выстрелил в голову курьеру из-за конфликта на дороге
Мужчина в Киеве выстрелил в голову курьеру из-за конфликта на дороге.Как отмечает в Telegram-канале украинское агентство УНИАН, выстрел, вероятно, был холостым.Подробности инцидента пока неизвестны.Несколько дней назад в кафе...
Врач Колесникова: вклад генетики в развитие алкогольной зависимости составляет до 65%
Склонность к любым типам зависимостей может быть наследственной, однако большую роль в их развитии играют факторы внешней среды. Об этом RT рассказала врач-генетик Ирина...
Продление упрощённой регистрации лекарств от COVID-19: в России за сутки выявлено 22 572 новых...
За прошедшие 24 часа в России зафиксировано 22 572 новых случая коронавирусной инфекции. С начала пандемии в стране выявлено 1 925 825 заболевших COVID-19....
Беженец Рубцов: жители Курахово не топили печи из-за БПЛА ВСУ с тепловизорами
Беженец из Курахово в ДНР Александр Рубцов рассказал, что жители города боялись топить печи из-за атак украинских БПЛА с тепловизорами.«Это украинские дроны были, они...
Орденами Мужества: Шойгу наградил лётчиков после инцидента с беспилотником США в небе над Чёрным...
Глава Минобороны РФ Сергей Шойгу вручил ордена Мужества лётчикам экипажей Су-27, предотвратившим нарушение границ района временного режима использования воздушного пространства американским беспилотником MQ-9. Сами...